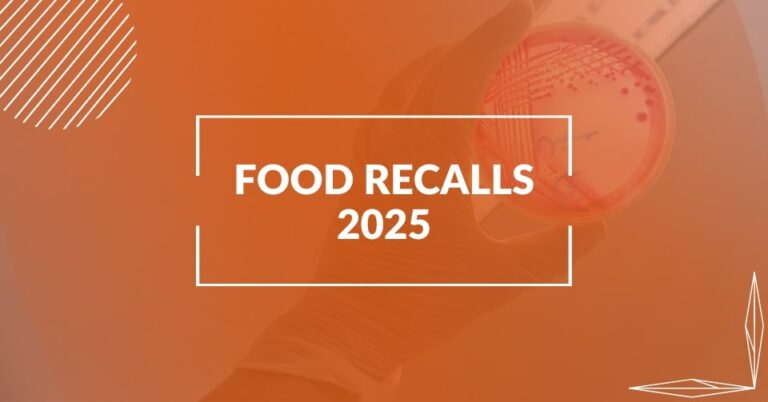
2025 FDA Food Recalls

AI-Powered
All-In-One Platform
Food Traceability Software
Food Production Software
Food Safety Software
Food Inventory Software
HACCP Plans
Food Quality Software
GFSI Audit Ready
FDA & USDA Ready
GFSI Certifications
Food Supplier Software
GMP Consulting
Food Safety Consulting
FSMA 204 Software
Use the power of automated & digital traceability, quality, inventory, production, HACCP, & food safety software powered by AI combined with expert food safety consulting for fast HACCP / State / FDA / USDA Compliance, FSMA 204, and SQF, GMP, cGMP, GFSI, BRCGS, FSSC Certifications.
Leading Companies Trust FoodReady
Our customers are supported by a unique combination of veteran food safety experts and software intelligence. We will get your Food Safety / HACCP programs ready to stay ready for any GFSI, BRC, SQF, or Retail Audit, in addition to State, USDA, or FDA inspections.
Hear It From Real People
Food Safety Software
FoodReady food safety software automation and consulting ensures clients are audit and inspection ready. Spend 70% less time on document management with our digital system saving time, space, and money. Obtain more efficient operations, certifications, product quality and grow your business with our food safety compliance software.
Audit Ready
We ensure clients are ready to pass their audits and inspections.
Return On Investment
Successful audits resulted in clients receiving significant retail contracts.
Time Saving
Clients saved up to 70% of their manual effort by switching to digital docs.
Happy Users
Over a thousand companies are using FoodReady software.
Our team will use our HACCP / PCP Plan builder to create your custom HACCP or Food Safety Plan. Use the mobile app to track Critical Control Points.
Our team can review the real time records and daily logs in your account to keep your process compliant and on track.
We can help establish policies, programs, procedures, traceability, and more to ensure you are ready for your audit or inspection.
Food Safety / Audit / HACCP & Quality Management Consulting
We establish food safety and quality management system certification programs, train you to implement the programs in parallel with automated software, and work with you to pass audits or inspections.
Engage with an expedient process than traditional consulting. Supported by a unique combination of veteran food safety experts and software intelligence, we get your Food Safety / HACCP programs ready to stay ready for any GFSI, BRC, SQF, or Retail Audit, in addition to State, USDA, or FDA inspections.
How Can Our Food Safety Management Software Help You?
Save time and hassle by using food safety compliance management software to reduce paperwork and improve the accuracy of your Food Safety / HACCP programs. “Get ready and stay ready” for any 3rd-party audit or regulatory inspection. Use the mobile app to track daily food operational checklists, receiving inventory, production runs, corrective actions, Bluetooth temperature logs, and more.
HACCP / PCP Plan Builder
Intuitive drag-and-drop process flow designer with click-and-choose hazard database to build your HACCP / PCP programs. Use any of the 80+ PCP / HACCP templates!
Operational Checklists
You can create custom checklists or choose from our vast checklist library of facility opening and closing procedures, inspection, sanitation procedures, quality, and more.
Batch & Inventory Database
Track your production runs, bill of materials, purchase orders, receiving & shipping traceability, inventory costs and more.
Traceability & Recall
Manage your lot traceability with shipping and receiving logs. These logs are also associated with sales and purchase orders to track the inventory.
Automated Supplier Document Management
Collecting and storing documentation from the suppliers of your ingredients is important to keep the food supply chain safe.
Real-Time Monitoring and Verification
The Monitoring feature allows you to view CCP and operational monitoring programs in one place. You can monitor moisture, or any other kinds of things in your facility as they occur in real time.
Awarded by Food & Beverage Technology Review
Top Food Safety Solutions Provider 2023
Ready to take the next step with us?
Food Safety Compliance & Certification
Hire our experienced food safety consultants and food safety software & compliance system to help you pass 3rd-party audits and regulatory inspections.
HACCP Consultant
Our HACCP Consultant will help you write and implement your HACCP Plan, Food Safety Plan, and develop your complete Food Safety Program.
FDA Consultant
Our FDA Consultant will help you prepare for FDA compliance along with creating any HACCP or PCP plans needed for your upcoming inspection.
SQF Consultant
Our SQF Consultant will help you prepare for and pass your SQF audit by creating a SQF compliant food safety system for your facility.
GFSI Consultant
Our GFSI Consultant will help you write and implement your HACCP Plan, Food Safety Plan, and develop your GFSI compliant Food Safety Program.
FSMA 204 Consultant
Ensure FSMA 204 compliance with our expert FSMA 204 Consultant. We specialize in planning and implementing tailored FSMA 204 programs effectively.
GMP Consultant
Our GMP Consultant will help you write and implement your HACCP Plan, Food Safety Plan, and develop your GMP audit-ready system.
Recent Posts

6 Katana Alternatives for Food & Beverage Manufacturers (2026 Guide)
If you run a food or beverage business, you already know: keeping inventory under control while staying compliant is a challenging task. You must watch

How AI Is Changing HACCP Documentation for Food Manufacturers?
Creating and maintaining a HACCP plan is one of the most important responsibilities in a food operation, and one of the most time-consuming. Teams often
FDA Food Recalls 2025 – Stay Updated on the Latest Alerts
Stay informed and protect your health with our weekly updated list of FDA food recalls in 2025. Each week, we compile the latest recalls, safety
We Can Help You Develop Your
Food Safety Documentation
Choose the Best Package for You
Food Safety Software & Consulting Services for anything – from large manufacturers to startups, from seafood processing to coffee roasting, from bakeries to kombucha brewers, from food service to grocers, caterers and restaurants. We are here to assist!
Restaurant / Grocery / Food Service
(HACCP)
- Certified HACCP Consultant
- HACCP Builder
- HACCP CCP Logs Mobile App
- Checklist Builder
- Standard Operating Procedures
- Document Version Control
Manufacturer / Processor Compliance
(FDA / USDA / STATE)
- Certified HACCP/PCQI Consultant
- Batch & Inventory Management
- Receiving & Shipping Traceability
- Recall & Mock Recall Management
- Verification Dashboard
- Supplier Document Management
- Operational & Quality Checklists
Enterprise
(GFSI / BRC / SQF / ISO / GMP)
- All from Manufacturer Compliance
- Veteran Quality & GFSI Consultant
- GFSI Policy Documents
- Environmental Monitoring App
- On-Site GAP Assessment
- Self-Audit Checklists
- Quality Record Reviews
Speak with our
Expert Consultants
Get a Free Consultation With Our Food Safety
and Quality Experts Today!